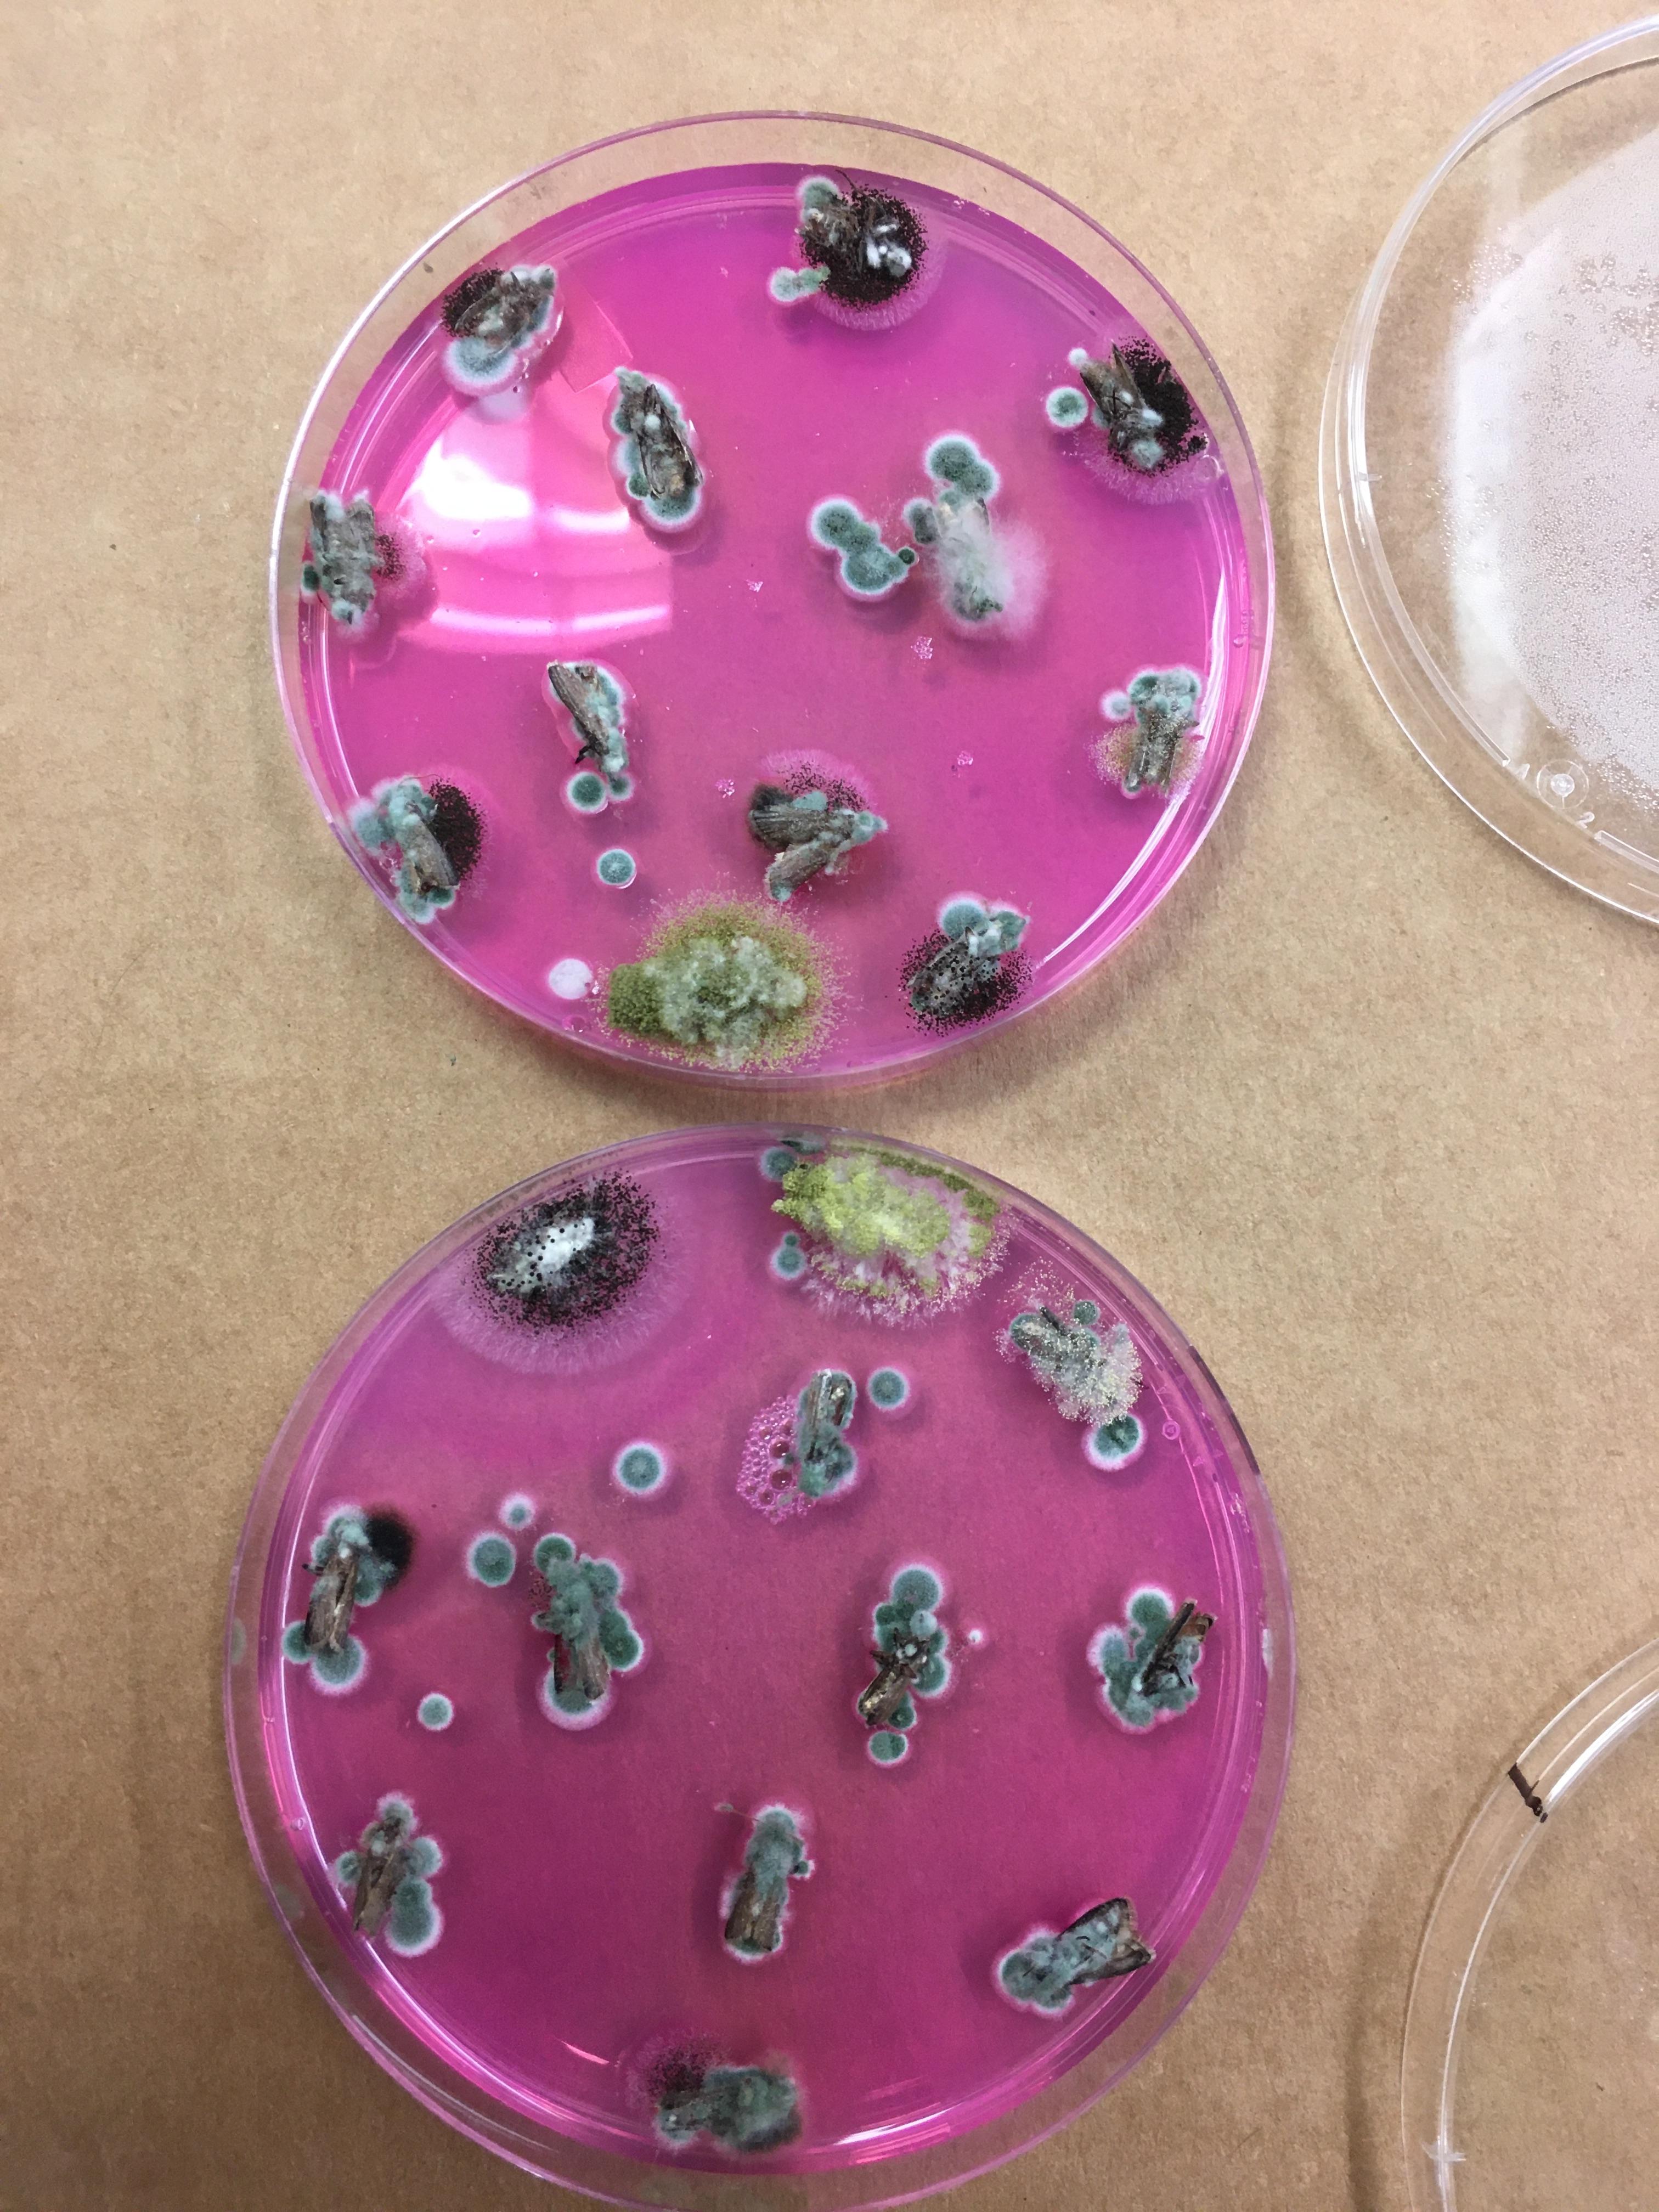

El cultivo de las almendras (Prunus armeníaca) fue introducido a la región de California (EEUU) desde España, aproximadamente a mediados de 1700. Ya para la mitad del 1900 estaban establecidas estas frutas secas en el Valle Central de este gran estado (el más agrícola de este país) desde el Valle de Sacramento en el Norte hasta el Valle de San Joaquín en el Sur. Según el último reporte CDFA (California Department of Food and Agriculture), en el 2019 California estimó un total de 1.530.000 acres (619.169 ha) de almendra, un 10% más que 2018.
Cifras que sorprenden
Del total de acres en el 2019, 1.180.000 acres (477.529 ha) en producción, y 350.000 (141. 639 ha) no productivas. Para el 2020 se estimó un total de 1.260.000 acres (509.903 ha) productivos. Nonpareil sigue siendo la principal variedad seguida por Monterrey, Butte, Carmel y Padre.
Los condados de Kern, Fresno, Stanislaus, Merced y Madera son los que nuclean más del 70% de la superficie en producción.
La cosecha estimada por acre al 2019 fue de 2160 libras (2420 kg/ha), con un precio de 2.4 dólares por libra (0.453 kg) (último valor publicado por USDA).

El ingeniero agrónomo sanjuanino Víctor Gabri, está realizando estudios de especialización en el Kearney Ag & Research Extension Center, que está ubicado en el condado de Fresno.
Esta semana lo consultamos sobre las novedades de relevancia en este particular cultivo, que junto con los pistachos y las nueces, tienen alta demanda mundial.
+Por ello numerosos productores y asesores de almendros traen muestras constantemente para sus consultas y evacuación de dudas de campo+, comenzó diciendo.
+De las enfermedades más importantes detectadas se puede resaltar: Podredumbre Marrón (Monilinia laxa), varias bacteriosis (Xanthomonas arboricola), Roya (Transzchelia discolor), Alternaria (Alternaria alternata), entre otras,+ continuó.
Ciencia hoy
+Actualmente el principal proyecto que tenemos en conjunto con la industria almendrera californiana es en aflatoxinas, una de las grandes preocupaciones para los productores. Esto en el equipo del Dr. Themis Michailides, experto de UC Davis.+
Le preguntamos al joven profesional y nos detalló +los objetivos fundamentales de este gran proyecto, basados en el uso de biocontrol, son encontrar básicamente tiempos y formas de aplicación, del producto bio control registrado para uso en almendro, son granos de sorgo inoculados con el hongo benéfico. Esto es para mejorar su eficiencia a campo, monitorear y evaluar áreas donde el producto fue utilizado y determinar la reducción en la contaminación con aflatoxinas.+
Prosiguió el investigador y extensionista +esto se desarrolla en campos comerciales distribuidos en las zonas productivas del Valle de California, e involucra la toma de muestras de suelo en diferentes etapas, y por supuesto las muestras de fruta de los montes comerciales.+

Consejos para el productor
Referidos a las enfermedades en general y al uso de productos, destacó Gabri que siempre se aconseja hacer uso de manejo de resistencia de fungicida, eficacia de fungicidas para enfermedades de almendro, tiempos de aplicación, para cada uno de estos manejos existen tablas desarrolladas por investigadores y asesores que son muy valiosas para los productores. Dijo posteriormente +las recomendaciones a campo que los productores acá llevan a cabo, son mayormente relacionadas al manejo de una polilla que funciona como un carrier del hongo que produce la toxina (NO es un vector). Este insecto se llama (Amyelois transitella). Estas labores agrícolas también consisten en la limpieza invernal, remover toda la almendra que quedó en el árbol de la temporada anterior y destruirla; se aconseja asimismo la cosecha temprana, ni bien la fruta esta lista se cosecha lo antes posible; y además de tratamientos en temporada que, si se logra manejar adecuadamente los dos primeros (cosecha temprana, y remoción de almendras que quedaron en el árbol) en tiempo y forma, puede no ser necesario.+
Los productos
Básicamente los que utilizan para el manejo de enfermedades mencionadas al comienzo:
Azoxystrobin, Difenoconazole-boscalid, Pyraclostrobin, Captan, Chlorothalonil Cyprodinil, Fluopyram, Tebuconazole-fluxapyroxad, Pyraclostrobin-penthiopyrad, entre otros.
Felicitamos a nuestro colega que realiza investigaciones técnicas de importancia en tierras californianas y los alentamos a continuar estos avances en su vuelta a San Juan.

509.903 hectáreas con almendras tiene, a la campaña 2020, el estado de California.
2.420 kilogramos por hectárea, fue la cosecha estimada en la temporada 2019.
2.4 dólares por libra (0.453 kg), fue el último precio publicado por USDA.
Por el Ing. Agr. Alejandro Acosta
Fotos: Gentileza Ing. Agr. Víctor Gabri
